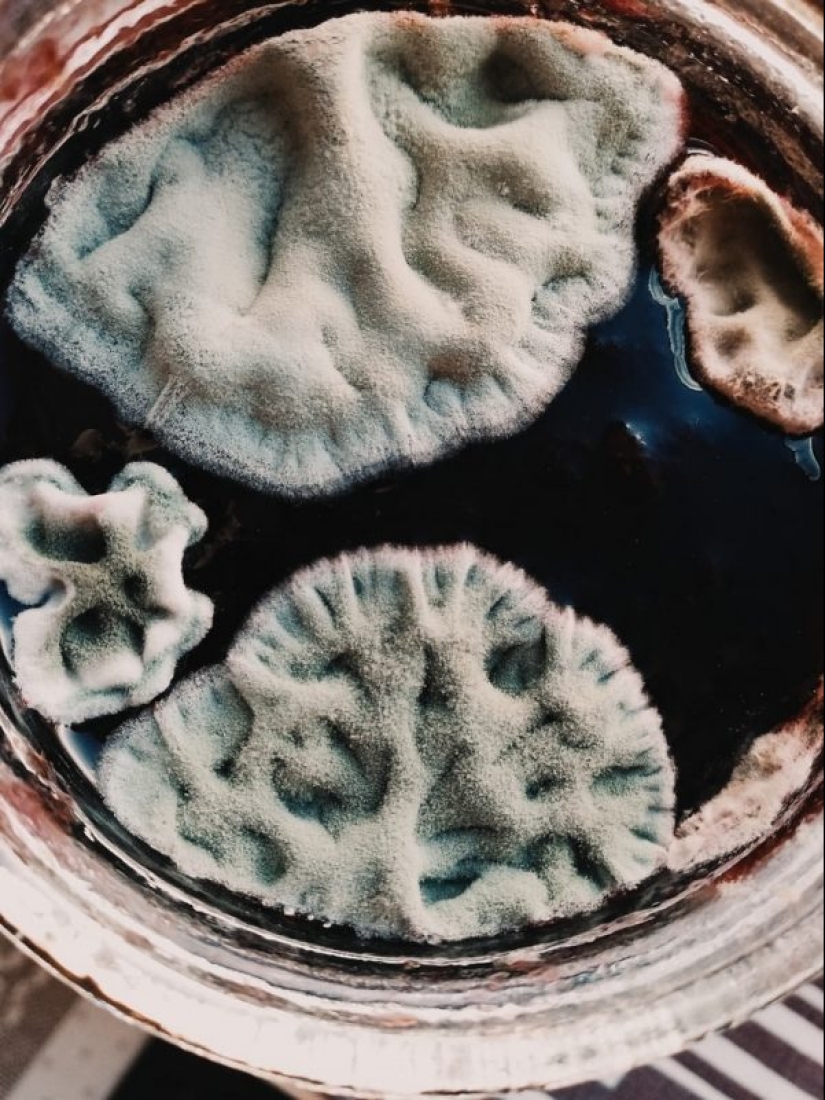
"VKontakte" hay una comunidad de estetas, los conocedores de molde

"VKontakte" hay una comunidad de estetas, los conocedores de molde
Categorias: Micromundo | Naturaleza | Redes sociales
Por Pictolic https://mail.pictolic.com/es/article/vkontakte-hay-una-comunidad-de-estetas-los-conocedores-de-molde.htmlHobby, fascinante para las personas modernas, es increíblemente diversa. Pocas personas hoy en día colecciona sellos o colas de los modelos de aviones — dar a todos extravagante Aficiones, que le permiten sobresalir entre la masa gris. A veces únicos encontrar personas de ideas afines y, a continuación, nacen en estas comunidades con los mismos intereses que el público "Vkontakte" llamado, "Madre, he planteado el molde".

Los suscriptores de este inusual de la comunidad están Unidos por una pasión común — que crecen en la nevera, en los alféizares de las ventanas y debajo de las camas pintoresca colonia del molde y, a continuación, publicar sus fotos en el grupo. A veces, la creación conjunta de los miembros y de naturaleza similar a los paisajes cósmicos, a veces, en los icebergs o de lujo atolones.

Brew
También sucede que, para encontrar una adecuada comparación con el resultado "obra maestra" no es fácil, y en virtud de la real debates se producen. Resulta que los expertos de moho y hongos en nuestro país no son tan poco y tienen algo de que hablar bajo el verde de los panes o cubierto con un intrincado toque de mandarina.
Mermelada de cereza
Público "Madre, he planteado el molde" en el más grande de rusia de la red social apareció en el año 2015. Fue fundada por un estudiante de medicina Sergey Merzlyakov y analista de Nikita Petrov. Preguntado por los periodistas acerca de lo que los inspiró a crear un inusual puesta en común de intereses, los chicos están dispuestos a contar su historia.

Aceitunas
Como resultó, todo comenzó en la comunidad "Feo plantas", donde alguien había publicado fotos de moho de la pasta. El tema parecía muy interesante y se decidió organizar una por separado público, donde todos pueden compartir las fotografías con alimentos en mal estado y de las cosas. Nadie se esperaba el éxito — sólo Sergei y Nikita estaba aburrido.

Trigo sarraceno
Los creadores de la comunidad nunca han estado interesados en el molde y fueron gratamente sorprendido de que ella puede ser atractivo. Sergey dice que ni siquiera había imaginado que "no puede haber tanta belleza." También dijo que en su juventud tenía miedo de artrópodos, como las arañas y los ácaros. Pero empecé a estudiar biología, él cambió su actitud a esas criaturas, y ahora se refiere a ellos con calma.
Mandarín
Por lo que dicen los creadores de este interesante pública y es difícil no estar de acuerdo. Ellos llaman a sus miembros, con cierto grado de ironía "con diligencia". Este término se origina a partir de un local meme, conocido por todos los asiduos de la pública, el origen de que Nikita y Sergey explica:

No identificados jam
Los mismos autores han sido durante mucho tiempo se dejaron crecer el moho, como el contenido original y de la comunidad vierte en una corriente sin fin. En la oficina de "Vkontakte" informó de que el público se ha convertido en el propietario de la marca "Prometeo", lo que llevó a la comunidad un 16% adicional de los participantes.

Arco

Los pepinos
Hay una Nikita y Serguei planes para el futuro? Por supuesto! Los chicos van a la liberación... propia marca de ropa. Ellos creen que por estar todavía es imposible, y Plesen suena bien. Principio de promoción de la marca debe ser — chicos vender la etiqueta engomada de paquetes con las telenovelas niña — un símbolo de la pública.
Palabras clave: Las setas | El grupo | El moho | La comunidad | La afición
Publicar artículo de noticiasArtículos Recientes

Ya es hora de admitir que toda esta idea hipster ha ido demasiado lejos. El concepto se ha vuelto tan popular que incluso los ...

Hay una percepción de que las personas sólo utilizan el 10% de su cerebro potencial. Pero los héroes de nuestra revisión, al ...
Artículos relacionados

Esta mujer combina dispares siglo XVII las cosas — ella era una monja, una rebelde y una bruja. Es tiro de arco, el ...

Científicos españoles dijo que las manzanas con tales imperfecciones como las manchas y las zonas de podredumbre que son ...

¿Qué sabemos del amor? Generalmente, todos los confinados a los dos hechos: se trata de un tradicional Japonés alcohol y que ...

Año Nuevo es una época para sorprender y deleitar a los seres queridos, no solo con regalos, sino también con una presentación ...